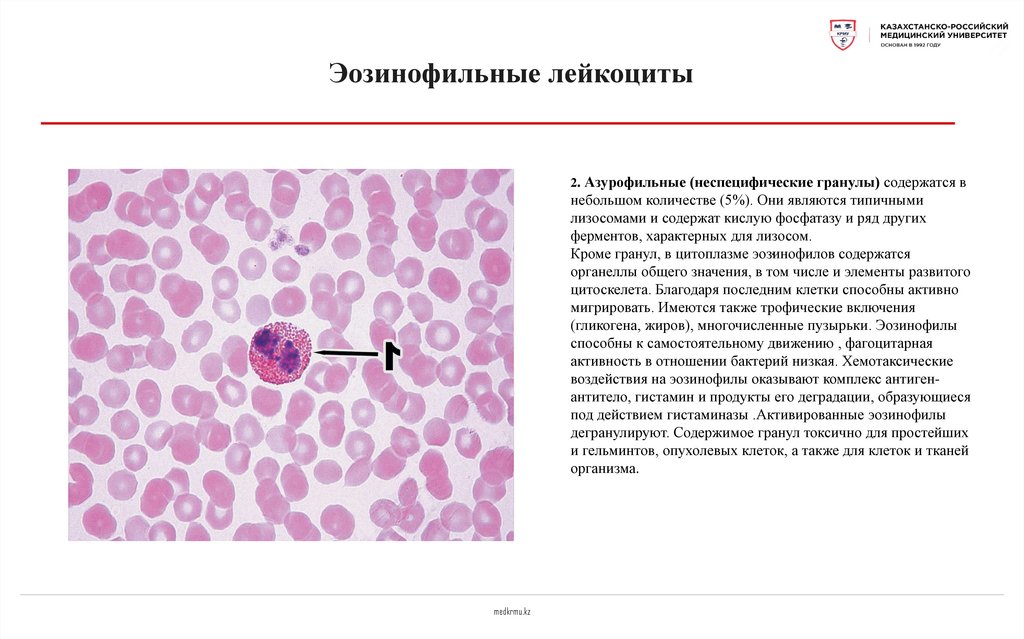
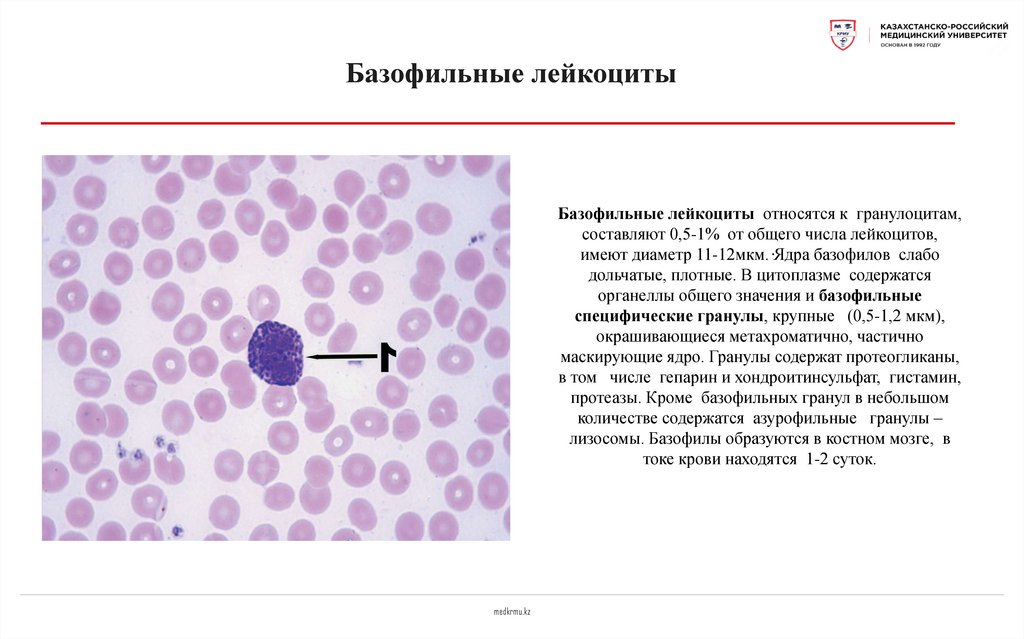
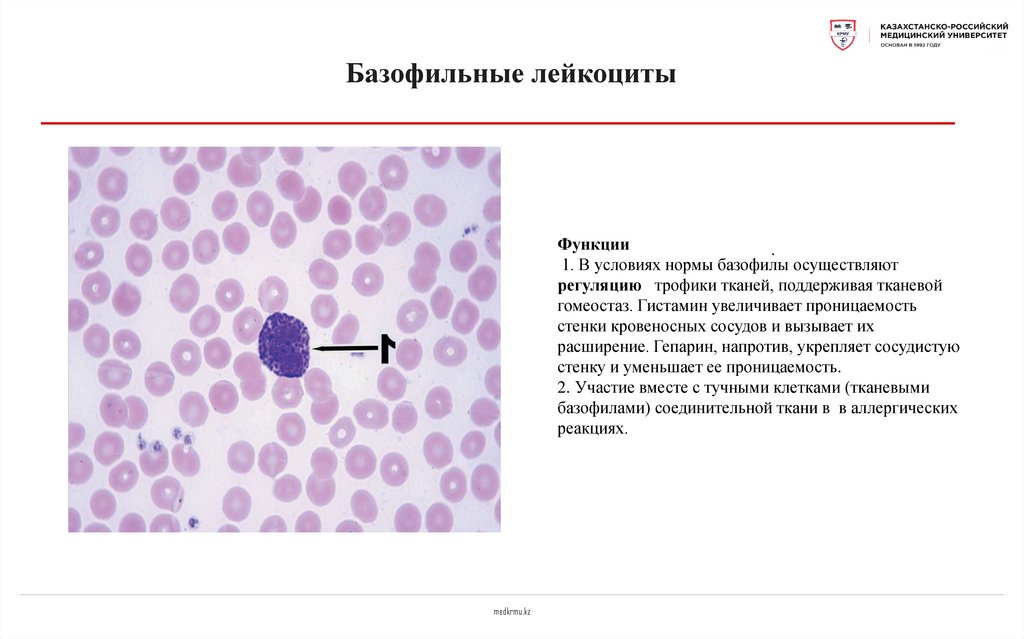
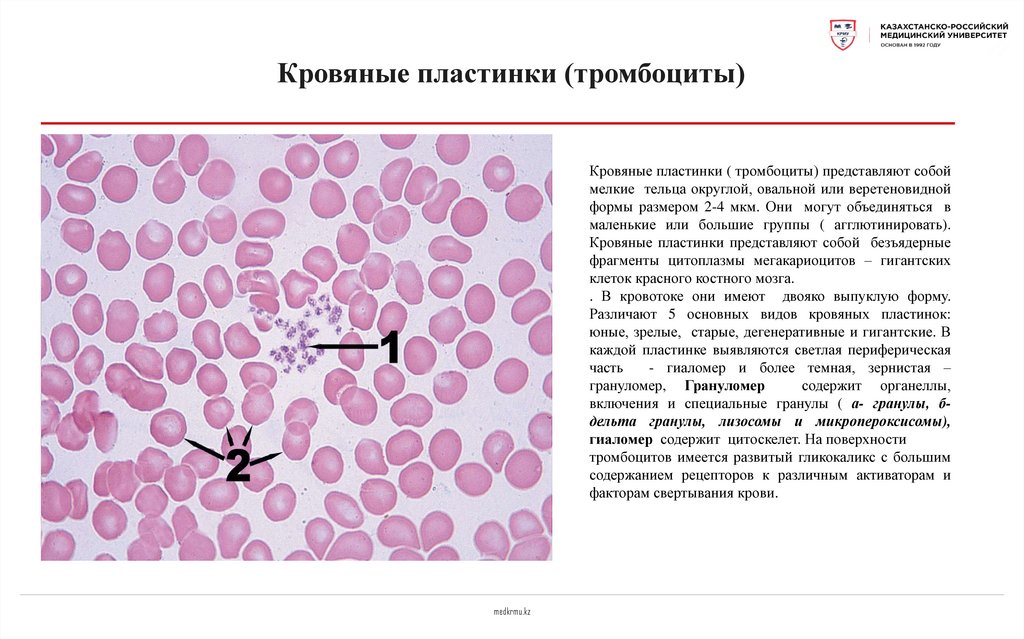
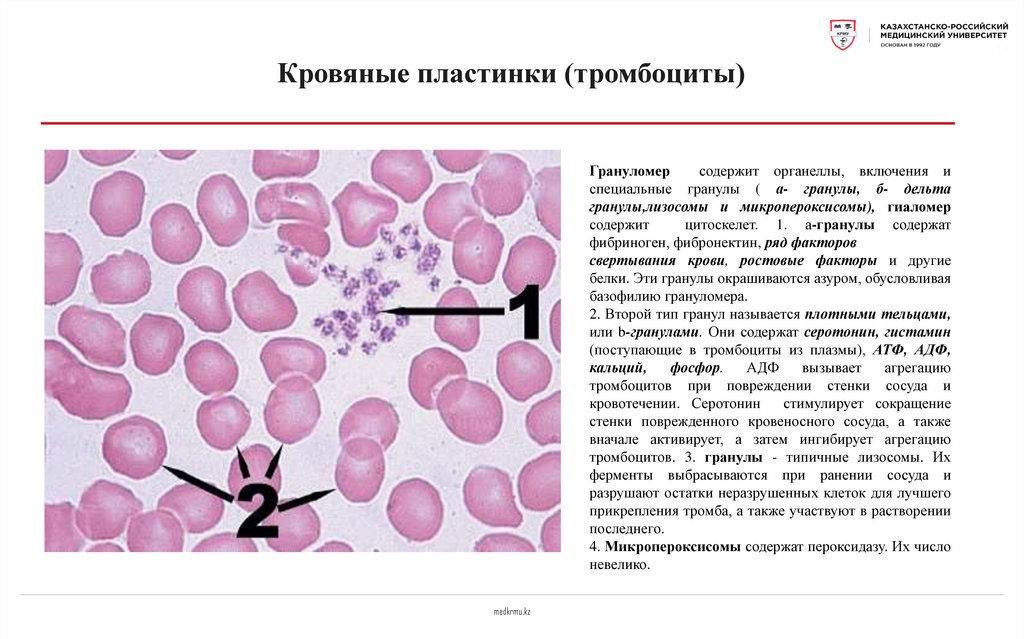
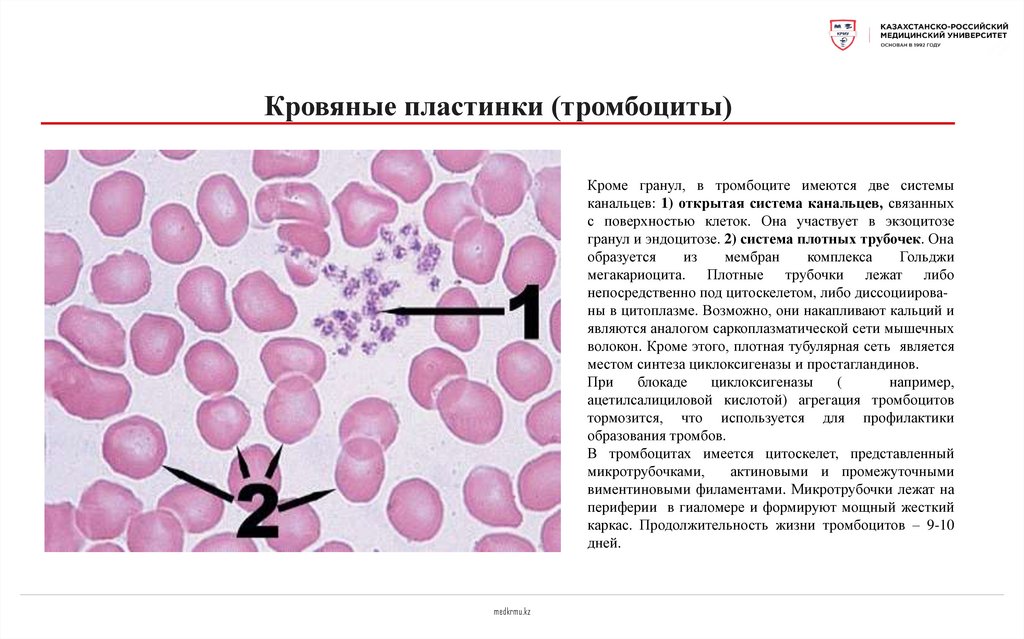

Similar presentations:
Кровь человека
1.
КРОВЬ ЧЕЛОВЕКАКафедра анатомии с курсом гистологии
Калинина М.С., доцент, канд. мед. наук
medkrmu.kz
2.
План лекции1. Общая характеристика крови;
2. Источники развития;
3. Эритроциты, строение и функции;
4. Классификация лейкоцитов, строение и
функции;
5. Кровяные пластинки.
medkrmu.kz
3.
Общая характеристика•Кровь - особая жидкая ткань , которая
относится к группе тканей внутренней среды.
Состоит из плазмы и форменных элементов.
•Плазма составляет 55 – 60% объема крови, а
форменные элементы – 40 – 45%.
•К форменным элементам относятся эритроциты,
лейкоциты и кровяные пластинки.
medkrmu.kz
4.
Общая характеристикаПлазма крови
представляет собой межклеточной вещество
жидкой консистенции, которое содержит 90-93% воды и 7-10%
сухого вещества, в плазме содержится около 6,6-8,5% белков и
1,5-3,5% других органических и минеральных соединений. К
основным
белкам плазмы крови относятся
альбумины,
глобулины и фибриноген. Белки
крови создают ее вязкость,
поддерживают онкотическое давление , обеспечивают коагуляцию
крови
и
разрушение
тромбов,
выполняют
защитные
(иммуноглобулины, комплемент и др.) и транспортные функции.
Антитела выделены из фракции глобулинов. Плазма крови имеет
рН около 7,36.
medkrmu.kz
5.
Функции•Кровь выполняет следующие функции:
•Защитную,
•Дыхательную,
•Трофическую,
•Выделительную,
•Регуляторную,
•Гомеостатическую.
medkrmu.kz
6.
Мазок крови человекаМазок крови человека. Окраска по Романовскому –
Гимза. Х 900
1 – эритроциты; 2 – лимфоциты (малый и большой);
3 – моноцит, 4 – нейтрофильные лейкоциты;
5 – эозинофильный лейкоцит;
6 – базофильный лейкоцит;
7 – кровяные пластинки (тромбоциты)
medkrmu.kz
7.
ЭритроцитыЭритроциты – безъядерные, высоко специализированные клетки,
утратившие в процессе развития ядро и все органеллы, их
относят к постклеточным структурам. Основная функция
эритроцитов - дыхательная, транспорт кислорода и углекислоты,
которая
обеспечивается гемоглобином, кроме этого они
участвуют в транспорте аминокислот, антител, токсинов и ряда
лекарственных веществ, адсорбируя
их на
поверхности
плазмолеммы.
Количество эритроцитов : у мужчин-4-5.5*1012/л и у женщин
– 3.9-4.9 *1012/л, однако оно может варьировать в зависимости от
возраста,
эмоциональной и мышечной нагрузки, действия
экологических факторов. Увеличение количества эритроцитов
называется эритроцитоз, уменьшение - анемия.
.
У мужчин: 4 -5,5 х1012/л; у женщин:3,9-4,9х1012/л.
medkrmu.kz
8.
ЭритроцитыЭритроциты в норме имеют форму двояковогнутого
диска ( дискоциты) и составляют 80-90%, кроме этого
встречаются
планоциты, сфероциты, эхиноциты,
стоматоциты. Диаметр большинства эритроцитов около
7,5мкм, остальная часть представлена микроцитами и
макроцитами.
Изменение
формы
эритроцитов
называется
пойкилоцитозом. Появление в крови эритроцитов
различной величины называется анизоцитозом.
Продолжительность жизни эритроцитов составляет 120
дней. Молодые формы эритроцитов – ретикулоциты
составляют 1-5%.
Важным показателем
является скорость оседания
эритроцитов (СОЭ), в норме она составляет 4-12
мм/час. Увеличение данного показателя происходит при
инфекционных, воспалительных и онкологических
заболеваниях,
medkrmu.kz
9.
ЭритроцитыПойкилоцитоз и анизоцитоз
Изменение формы эритроцитов называется
пойкилоцитозом. Появление в крови
эритроцитов различной величины
называется анизоцитозом.
medkrmu.kz
10.
ЭритроцитыРетикулоциты (1-5%).
Ретикулоциты – молодые формы
эритроцитов, в которых при
специальной окраске крезиловым
или метиловым синим выявляется
нежная сеточка, представляющая
собой остатки органелл.
medkrmu.kz
11.
Эритроциты1-плазмолемма, 2-белок полосы 3, 3гликофорин, 4-спектрин, 5-анкирин, 6белок полосы 4.1, 7-узловой комплекс, 8актин.
Плазмолемма эритроцитов состоит из
бислоя липидов и белков, а также
небольшого
количества углеводов,
формирующих гликокаликс.
medkrmu.kz
12.
Эритроциты1-плазмолемма, 2-белок полосы 3, 3гликофорин, 4-спектрин, 5-анкирин, 6белок полосы 4.1, 7-узловой комплекс, 8актин.
В
плазмолемме
эритроцитов
содержится
15
главных белков,
основная масса которых представлена
примембранным белком- спектрином и
трансмембранными
белкими
гликофорином и полосой 3. На
поверхности эритроцитов у 86% людей
имеется резус- фактор.
medkrmu.kz
13.
Эритроциты1-плазмолемма, 2-белок полосы 3, 3гликофорин, 4-спектрин, 5-анкирин, 6белок полосы 4.1, 7-узловой комплекс, 8актин.
Спектрин
является
белком
цитоскелета и участвует в поддержании
двояковогнутой формы эритроцита.
Гликофорин- трансмембранный белок,
выполняющий рецепторную функцию,
а белок полосы 3
многократно
пересекает бислой липидов и участвует
в обмене кислорода и углекислого газа.
medkrmu.kz
14.
ЛейкоцитыКоличество лейкоцитов - 3-8х109/л
medkrmu.kz
15.
ЛейкоцитыЛейкоциты подразделяются на гранулоциты (зернистые)
и агранулоциты (незернистые).
Гранулоциты имеют в
сегментированные ядра.
цитоплазме
окрашенные
гранулы
и
В зависимости от окрашивания гранул различают: нейтрофильные,
эозинофильные и базофильные лейкоциты.
Агранулоциты не имеют специфически окрашенных гранул и делятся
на моноциты и лимфоциты.
medkrmu.kz
16.
Нейтрофильные лейкоцитыНейтрофильные лейкоциты относятся к гранулоцитам,
составляют самую многочисленную группу (48-75% от общего
числа лейкоцитов), имеют диаметр 10-12мкм, подразделяются
на юные (0-1%), палочкоядерные (1-5%) и сегментоядерные зрелые. В зрелом нейтрофиле ядро состоит из 3-5 сегментов,
соединенных перемычками. Цитоплазма слабо оксифильная,
содержит два типа гранул: специфические и азурофильные.
Специфические гранулы мелкие (0,2мкм), более
многочисленные, составляют 80-90% всех гранул,
окрашиваются и кислыми и основными красителями в розовофиолетовый цвет (нейтрально), содержат лизоцим, щелочную
фосфатазу, лактоферрин, катионные и адгезивные белки.
Азурофильные гранулы более крупные являются первичными
лизосомами, содержат лизосомальные ферменты.
Продолжительность жизни нейтрофилов составляет около 8
суток. В токе крови нейтрофилы находятся 1-2 суток. Свои
основные функции они выполняют в тканях.
medkrmu.kz
17.
Нейтрофильные лейкоцитыКроме гранул, в цитоплазме нейтрофилов находятся
митохондрии, слабо развиты ЭПС и комплекс Гольджи и
цитоскелет. В ядрах нейтрофилов преобладает гетерохроматин,
в связи с чем они интенсивно окрашиваются основными
красителями. Форма ядер зависит от степени зрелости
нейтрофилов (юные, палочкоядерные (1), сегментоядерные) . У
женщин ядра нейтрофилов содержат инактивированную вторую
Х-хромосому в виде барабанной палочки.
При активации нейтрофилов в них происходит так называемый
“респираторный взрыв”: резкое усиление окислительных
процессов с образованием активных форм кислорода,
губительных для бактерий.
medkrmu.kz
18.
Нейтрофильные лейкоцитыФункции нейтрофилов :
1. Фагоцитоз. И.И. Мечников назвал их
микрофагами. Нейтрофилы фагоцитируют в основном мелкие частицы и
микроорганизмы в отличие от макрофагов, способных к фагоцитозу
более крупных частиц.
2. Осуществление нефагоцитарного типа бактерицидности путем
секреции бактерицидных факторов, в том
числе ферментов,
бактериостатических и бактерицидных белков, активных метаболитов
кислорода.
3. Поддержание тканевого гомеостаза.
4.Секреторная и регуляторная функции нейтрофилов заключаются в
выделении различных медиаторов, регулирующих другие тканевые
клетки,
состояние межклеточного вещества, иммунные реакции,
репаративные процессы.
medkrmu.kz
19.
Эозинофильные лейкоцитыЭозинофильные
лейкоциты
относятся к
гранулоцитам, составляют 1-5% от общего числа
лейкоцитов, имеют диаметр
12-14мкм. Ядра
.
эозинофилов имеют , как правило, 2 сегмента,
соединенных перемычкой. В цитоплазме содержатся
органеллы
общего
значения,
специфические
эозинофильные гранулы и азурофильные гранулылизосомы. 1.Специфические гранулы окрашиваются
в красный цвет, их размеры 0,6-1мкм, содержат
главный основной белок, эозинофильный катионный
белок,
эозинофильный нейротоксин, гистаминазу.
Эозинофильные лейкоциты образуются в костном
мозге, в токе крови находятся 12 часов
medkrmu.kz
20.
Эозинофильные лейкоциты2. Азурофильные (неспецифические гранулы) содержатся в
небольшом количестве (5%). Они являются типичными
лизосомами и содержат кислую фосфатазу и ряд других
ферментов, характерных для лизосом.
.
Кроме гранул, в цитоплазме эозинофилов
содержатся
органеллы общего значения, в том числе и элементы развитого
цитоскелета. Благодаря последним клетки способны активно
мигрировать. Имеются также трофические включения
(гликогена, жиров), многочисленные пузырьки. Эозинофилы
способны к самостоятельному движению , фагоцитарная
активность в отношении бактерий низкая. Хемотаксические
воздействия на эозинофилы оказывают комплекс антигенантитело, гистамин и продукты его деградации, образующиеся
под действием гистаминазы .Активированные эозинофилы
дегранулируют. Содержимое гранул токсично для простейших
и гельминтов, опухолевых клеток, а также для клеток и тканей
организма.
medkrmu.kz
21.
Эозинофильные лейкоцитыФункции:
1. Участие в аллергических реакциях: захват комплекса
антиген - антитело, медиаторов аллергических реакций и их
разрушение. Эозинофилы осуществляют поглощение и
разрушение гистамина, лейкотриенов, выделяющихся при
аллергических реакциях
.
2. Регуляторная функция. Вырабатываемые
и
секретируемые эозинофилами медиаторы регулируют
функции других клеток крови, участвующих в иммунных
процессах: базофилов, тучных клеток, Т- и В-лимфоцитов.
3. Защита организма от паразитов и опухолевых клеток:
эозинофилы с помощью комплемента связываются с
паразитом (опухолевой клеткой), при помощи белковперфоринов повреждают оболочку паразитов, проникают
внутрь их, вызывая гибель
. 4.Захват и разрушение токсинов, выделяемых
микроорганизмами.
medkrmu.kz
22.
Базофильные лейкоцитыБазофильные лейкоциты относятся к гранулоцитам,
составляют 0,5-1% от общего числа лейкоцитов,
имеют диаметр 11-12мкм. .Ядра базофилов слабо
дольчатые, плотные. В цитоплазме содержатся
органеллы общего значения и базофильные
специфические гранулы, крупные (0,5-1,2 мкм),
окрашивающиеся метахроматично, частично
маскирующие ядро. Гранулы содержат протеогликаны,
в том числе гепарин и хондроитинсульфат, гистамин,
протеазы. Кроме базофильных гранул в небольшом
количестве содержатся азурофильные гранулы –
лизосомы. Базофилы образуются в костном мозге, в
токе крови находятся 1-2 суток.
medkrmu.kz
23.
Базофильные лейкоцитыФункции
.
1. В условиях нормы базофилы осуществляют
регуляцию трофики тканей, поддерживая тканевой
гомеостаз. Гистамин увеличивает проницаемость
стенки кровеносных сосудов и вызывает их
расширение. Гепарин, напротив, укрепляет сосудистую
стенку и уменьшает ее проницаемость.
2. Участие вместе с тучными клетками (тканевыми
базофилами) соединительной ткани в в аллергических
реакциях.
medkrmu.kz
24.
ЛимфоцитыЛимфоциты относятся к агранулоцитам, составляют 1840% от общего числа всех лейкоцитов. По величине они
.
делятся на
малые (диаметром
4,5-6мкм), средние (
диаметром 7-10мкм), большие (диаметром 10 и более).
Большие лимфоциты встречаются у новорожденных и
детей, у взрослых они отсутствуют.
Для всех видов лимфоцитов
характерно
наличие
интенсивно окрашенного ядра округой или бобовидной
формы и узкого ободка базофильной цитоплазмы. В
цитоплазме
обнаруживаются
везикулы,
лизосомы,
рибосомы, полисомы, митохондрии, аппарат Гольджи,
эндоплазматическая сеть. Малые лимфоциты составляют
большую часть всех лимфоцитов крови( 85-90%). Среди
них различают светлые и темные. Малые темные меньше
светлых, имеют более плотное ядро и более узкий ободок
цитоплазмы, в которой расположено много рибосом.
medkrmu.kz
25.
ЛимфоцитыСредние лимфоциты составляют
10-12% лимфоцитов,
.
ядра у них округлые, хроматин более рыхлый, ядрышко
хорошо выражено, в цитоплазме содержатся все
органеллы. Кроме типичных лимфоцитов
в крови
человека встречаются лимфоплазмоциты(1-2%), которые
отличаются концентрическим расположением вокруг ядра
канальцев эндоплазматической сети. Основной функцией
лимфоцитов является их участие в иммунных реакциях.
Среди лимфоцитов различают
три основных
функциональных класса: Т- лимфоциты,
В- лимфоциты и нулевые лимфоциты. Продолжительность
жизни лимфоцитов варьирует от нескольких недель до
нескольких лет.
medkrmu.kz
26.
ЛимфоцитыТ-лимфоциты дифференцируются из стволовой клетки в
тимусе под влиянием тимических гормонов. В
функциональном отношении Т-лимфоциты подразделяются на Т-киллеры (цитотоксические), Т-хелперы,
Т-супрессоры и Т-лимфоциты памяти. Т-киллеры, или
цитотоксические Т-лимфоциты,
участвуют в реакциях
.
клеточного иммунитета. Т-хелперы несут на своей
поверхности CD4-антиген (CD4-позитивные
лимфоциты). Они стимулируют реакции клеточного и
гуморального иммунитета. Т-лимфоциты памяти являются
долгоживущими лимфоцитами, сохраняющими информацию
об антигене в течение длительно времени и реализующие
иммунные реакции при повторном контакте с ним.
В-лимфоциты у птиц развиваются в бурсе Фабрициуса, а у
человека и других млекопитающих - в красном костном
мозге. В периферических органах иммуногенеза они после
бласттрансформации превращаются в плазмоциты, которые
вырабатывают антитела, инактивирующие антигены (т.е.
участвуют в гуморальном иммунитете).
medkrmu.kz
27.
МоноцитыМоноциты - самые крупные клетки крови,
относятся к агранулоцитам, составляют 6-8% от
общего числа лейкоцитов, их диаметр достигает
18-20 мкм. Ядра у моноцитов крупные, имеют
бобовидную или подковообразную форму,
располагаются эксцентрично. Цитоплазма слабо
базофильная (бледно-голубая), в ней содержится
много лизосом. Моноциты относятся к системе
мононуклеарных
фагоцитов
или
к
макрофагической системе. В токе крови они
циркулируют 36-104 часа, затем выселяются в
ткани и превращаются в макрофагов.
medkrmu.kz
28.
МоноцитыФункции моноцитов.
1. Участие в неспецифических защитных
реакциях с помощью фагоцитоза .
2. Реализация специфических (иммунных)
защитных реакций: процессинг (переработка) и
презентация (представление)антигенов
лимфоцитам, выработка медиаторов иммунных
реакций, киллинг(разрушение) чужеродных
клеток.
3. Участие в противоопухолевой защите.
Макрофаги вырабатывают фактор некроза
опухолей , который вызывает апоптоз
опухолевых клеток.
4. Регуляторная функция - синтез медиаторов,
называемых монокинами.
5. Участие в поддержании тканевого
гомеостаза..
medkrmu.kz
29.
Кровяные пластинки (тромбоциты)Кровяные пластинки ( тромбоциты) представляют собой
мелкие тельца округлой, овальной или веретеновидной
формы размером 2-4 мкм. Они могут объединяться в
маленькие или большие группы ( агглютинировать).
Кровяные пластинки представляют собой безъядерные
фрагменты цитоплазмы мегакариоцитов – гигантских
клеток красного костного мозга.
. В кровотоке они имеют двояко выпуклую форму.
Различают 5 основных видов кровяных пластинок:
юные, зрелые, старые, дегенеративные и гигантские. В
каждой пластинке выявляются светлая периферическая
часть
- гиаломер и более темная, зернистая –
грануломер, Грануломер
содержит органеллы,
включения и специальные гранулы ( а- гранулы, бдельта гранулы, лизосомы и микропероксисомы),
гиаломер содержит цитоскелет. На поверхности
тромбоцитов имеется развитый гликокаликс с большим
содержанием рецепторов к различным активаторам и
факторам свертывания крови.
medkrmu.kz
30.
Лейкоцитарная формулаЛЕЙКОЦИТАРНАЯ ФОРМУЛА.
Строение и состав периферической крови характеризуются достаточно
жестким постоянством, что обеспечивает гомеостаз организма. Поэтому
изучение крови в клинических условиях позволяет получить достаточно
важную информацию об общем состоянии организма больного. При этом в
клинике наиболее часто используются такие показатели, как лейкоцитарная
формула и гемограмма. Лейкоцитарная формула представляет собой
процентное содержание всех видов лейкоцитов крови.
Гранулоциты
Агранулоциты
Нейтрофильные лейкоциты
юные
Палочко- Сегментоядерные ядерные
0 - 1%
1 - 5%
medkrmu.kz
48 -75 %
Эозинофилы
Базофилы
0 - 1%
1 – 5%
Лимфоциты
Моноциты
18-40%
2-9%
31.
Кровяные пластинки (тромбоциты)Грануломер
содержит органеллы, включения и
специальные гранулы ( а- гранулы, б- дельта
гранулы,лизосомы и микропероксисомы), гиаломер
содержит
цитоскелет. 1. а-гранулы содержат
фибриноген, фибронектин, ряд факторов
свертывания крови, ростовые факторы и другие
белки. Эти гранулы окрашиваются азуром, обусловливая
базофилию грануломера.
2. Второй тип гранул называется плотными тельцами,
или b-гранулами. Они содержат серотонин, гистамин
(поступающие в тромбоциты из плазмы), АТФ, АДФ,
кальций,
фосфор.
АДФ
вызывает
агрегацию
тромбоцитов при повреждении стенки сосуда и
кровотечении. Серотонин
стимулирует сокращение
стенки поврежденного кровеносного сосуда, а также
вначале активирует, а затем ингибирует агрегацию
тромбоцитов. 3. гранулы - типичные лизосомы. Их
ферменты выбрасываются при ранении сосуда и
разрушают остатки неразрушенных клеток для лучшего
прикрепления тромба, а также участвуют в растворении
последнего.
4. Микропероксисомы содержат пероксидазу. Их число
невелико.
medkrmu.kz
32.
Ультрамикроскопическое строение тромбоцитаУльтрамикроскопическое строение тромбоцита
(кровяной пластинки)
(по Н.А. Юриной).
А – горизонтальный срез;
Б – поперечный срез;
1 – плазмолемма с гликокаликсом;
2 – открытая система каналов, связанная с
инвагинациями плазмолеммы;
3 – актиновые филаменты;
4 – циркулярные пучки микротрубочек;
4а – микротрубочки в поперчном разрезе;
5 – плотная тубулярная система;
6 - -гранулы;
7 - -гранулы;
8 – митохондрии;
9 – гранулы гликогена;
10 – гранулы ферритина;
11 – лизосомы;
12 – пероксисомы.
medkrmu.kz
33.
Кровяные пластинки (тромбоциты)Кроме гранул, в тромбоците имеются две системы
канальцев: 1) открытая система канальцев, связанных
с поверхностью клеток. Она участвует в экзоцитозе
гранул и эндоцитозе. 2) система плотных трубочек. Она
образуется
из
мембран
комплекса
Гольджи
мегакариоцита. Плотные трубочки лежат либо
непосредственно под цитоскелетом, либо диссоциированы в цитоплазме. Возможно, они накапливают кальций и
являются аналогом саркоплазматической сети мышечных
волокон. Кроме этого, плотная тубулярная сеть является
местом синтеза циклоксигеназы и простагландинов.
При
блокаде
циклоксигеназы
(
например,
ацетилсалициловой кислотой) агрегация тромбоцитов
тормозится, что используется для профилактики
образования тромбов.
В тромбоцитах имеется цитоскелет, представленный
микротрубочками,
актиновыми и промежуточными
виментиновыми филаментами. Микротрубочки лежат на
периферии в гиаломере и формируют мощный жесткий
каркас. Продолжительность жизни тромбоцитов – 9-10
дней.
medkrmu.kz
34.
ГемограммаГемограмма - это абсолютное содержание
форменных
элементов
крови
(эритроцитов,
лейкоцитов, кровяных пластинок- тромбоцитов).
Кроме этого, в гемограмму входят следующие
показатели: содержание ретикулоцитов; скорость
оседания
эритроцитов
(СОЭ);
содержание
гемоглобина; гематокрит, а также лейкоцитарная
формула.
medkrmu.kz
35.
Возрастные особенности кровиПосле рождения существенно меняются практически все морфологические показатели крови..
Так, количество эритроцитов у новорожденных увеличено до 6-7х1012/л, к 2-недельному возрасту
достигает уровня взрослых, и продолжает снижаться до минимума к 3-6-му месяцам жизни
(физиологическая анемия). Количество эритроцитов становится таким же как и во взрослом
организме в период полового созревания. У новорожденных отмечаются анизоцитоз и
ретикулоцитоз (увеличение количества ретикулоцитов). При старении количество эритроцитов
может снижаться.
При рождении отмечается физиологический лейкоцитоз (до 10-30х109/л). Дефинитивный уровень
устанавливается к 14-и годам. В результате изменения соотношений количества нейтрофилов и
лимфоцитов в лейкоцитарной формуле имеют место физиологические перекресты.
У новорожденного процентное содержание этих форм лейкоцитов примерно равно их уровням у
взрослого человека. Первый перекрест отмечается на 3-4-е сутки жизни. К этому времени
содержание этих клеток уравнивается из-за падения доли нейтрофилов и увеличения содержания
лимфоцитов. Дальнейшие изменения ведут к тому, что к 1-2 годам жизни содержание нейтрофилов
становится равным 25%, а лимфоцитов -65%. В последующие 2-3 года наблюдается обратный
процесс, и в 4 -года наблюдается второй перекрест. К 14-и годам показатели соответствуют
таковым у взрослых людей. При старении могут наблюдаться снижение как абсолютного
содержания лейкоцитов, так и сдвиги в лейкоцитарной формуле.
medkrmu.kz
36.
СПАСИБО ЗА ВНИМАНИЕ!@medkrmu
vk.com/medkrmu
facebook.com/medkrmu
@medkrmu
По любым вопросам обращаться: 8 701 478 19 40
Электронная почта:
medkrmu.kz

medicine
medicine








